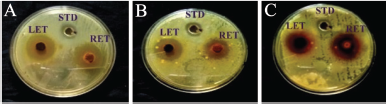

1. INTRODUCTION
In modern time, human beings are facing a serious threat from various water-or foodborne bacterial diseases. Amongst them, diarrhoea (caused by the intestinal pathogen) is one of the major concerns, as it is responsible for primary causes of infant mortality especially in the developing countries [1]. More specifically, cholera which is a severe form of acute secretory diarrhoea is the second leading cause of mortality worldwide among children under 5 years and also does the cause of morbidity in adults [2,3]. According to the World Health Organization (WHO), it is estimated that the more than one million people are reported by acute diarrhoeal cases annually due to Vibrio cholerae infection [4]. Cholera caused by V. cholerae is one of the most notorious enteric pathogens responsible for many cholera outbreaks, which are motile, Gram negative, comma shape belonging to the family Vibrionaceae [5]. There are approximately 200 recognized serogroups, of which serogroup O1 and O139 are associated with cholera epidemics in humans [6]. The cholera toxin (also known as choleragen) is a protein complex which is secreted by V. cholerae mainly responsible for causing copious, painful, watery diarrhoea, leading to vomiting, severe dehydration, and even death (if the treatment is not so prompt or even if too late) [7,8].
The emergence and spread of multidrug resistant pathogenic bacteria have created the need for the development of novel therapeutic agents. For which, plants are considered as the best sources of natural products as it cures various diseases from an ancient era [9–11]. Moreover, the WHO certified that more than 80% of the World’s population relies on traditional medicine for their primary health care needs [12]. During the second half of the 20th century, the acceptance of traditional medicine is increased terrifically and become an alternative option in modern health care as it has no/less side effects [13,14]. Different plant species containing a wide ranges of natural products are screened for vibriocidal activities and suggested that the plants are the best potential sources to treat cholera caused by some selective strains of Vibrio spp. [15]. It has been also reported that the plants, such as Morinda citrifolia, Ganophyllum falcatum, Leea aequata, Lawsonia inermis, Saraca indica, Syzygium cumini, Terminalia belerica, Allium sativum, and Datura stramonium, are having better effectiveness against a vibriocidal activity with different solvent extracts [16,17]. Most bactericides have harmful effects on the environments so, natural substances attracted wide interest, while secondary metabolites from higher plants serve as defensive agents against invading microorganisms [18].
Maranta arundinacea L. (commonly known as arrowroot plant) belongs to the family Marantaceae is a medicinally as well as economically important plant. Due to its starchy rhizome, it is widely cultivated in India which yields an easily digestible starch. Rhizome parts are used in confectionery for making of biscuits and weaned foods. Medicinally, the rhizomes are utilized for various digestive disorders, such as abdominal pain, indigestion, acidity, and irritation on the gastrointestinal system [19,20]. The plant is also well known for its anti-inflammatory, antiseptic, and antioxidant properties [21]. It was also reported that the plant is best effective against diarrhoea when applied with castor oil (studied in rat model) [22]; however, no such evidence is found regarding its vibriocidal activity. Hence, the present study is undertaken to evaluate the vibriocidal activity of leaf and rhizome extracts of M. arundinacea against V. cholerae.
2. MATERIALS AND METHODS
2.1. Collection of Plant Material
Rhizomes of M. arundinacea were collected from the coastal fertile belt of Cuttack, Odisha during the month of February 2013 and planted in the garden of Post Graduate Department of Botany, Utkal University (Fig. 1). After the identification by Dr. P.C. Panda, Principal Scientist, Regional Plant Resource Centre (RPRC), Bhubaneswar and deposition of the specimen with accession number BOTU10573, the further work was carried out within the laboratory.
 | Figure 1: Collection of healthy leaves and rhizomes from garden grown plants of M. arundinacea. (A) Healthy plants grown on natural condition; (B) freshly harvested leaves and (C) freshly harvested rhizomes. [Click here to view] |
2.2. Preparation of Various Solvent Extracts of M. arundinacea
The healthy leaves and rhizomes were harvested, washed under running tap water, cut into small pieces, and allowed to air dry up to achieve a constant weight. After drying, the plant materials were subjected to extraction by using different solvents systems [aqueous, ethanol (100%), hexane (100%), and methanol (100%)] with the help of Soxhlet apparatus for 48 hours. The obtained crude extracts were concentrated by rotary evaporator at reduced pressure and stored at 4°C for further analysis.
2.3. Microorganisms
The microorganisms used in this investigation included three bacterial strains of V. cholerae, such as SPAB1, SPAB4, and SPAB5. The isolated bacteria were identified based on morphological and biochemical characters. Identification and confirmation of V. cholerae at the molecular level was done by 16s r RNA sequencing and submitted to NCBI GenBank having accession number KT985959.1, KT985960.1 and KT985961.1 against SPAB1, SPAB4, and SPAB5, respectively.
2.4. Evaluation of Vibriocidal Activity of Plant Extracts
2.4.1. Agar Well Diffusion Assay
Agar well diffusion method initially tried for the screening of vibriocidal activity and was carried out as per the method of Pervez et al. [23]. Mueller Hinton Agar plates were swabbed with sterile cotton swabs by taking broth culture of V. cholerae. This procedure was repeated by twice and rotated the plates approximately 60° each time for even distribution of the inoculums. Wells (6 mm diameter) were made in each of these plates using cork borer. Each extract was checked for vibriocidal activity by introducing 250 µl of 100 mg/ml concentration into the wells by using sterile micropipettes. The plates were incubated at 37°C for 24 hours. After incubation, the zone of inhibition was measured and expressed in millimeters (mm). Ofloxacin (30 µg) was used as a positive control.
2.4.2. Determination of Minimum Inhibitory Concentration
The evaluation of MIC was determined by applying the method of Akinpelu and Kolawole [24]. The different concentrations of extracts (20–200 µg/ml) were used with the simple dilution processes. Ofloxacin is taken as a standard drug for the vibrocidal activity. MIC was recorded as the lowest extracts of concentration demonstrating no visible growth in the broth.
2.5. Statistical Analysis
All the results are the mean of three independent experimental replicates (n = 6) and data are reported as the mean ± standard error.
3. RESULTS AND DISCUSSION
3.1. Well Diffusion Analysis
The various solvent (aqueous, ethanol, hexane, and methanol) extracts from the leaf and rhizome samples of M. arundinacea showed various degrees of the inhibition against three strains of V. cholerae (Table 1). The results are presented by assessing the inhibition of bacterial growth and compared to that of the control (Ofloxacin). The growth inhibition zone measured ranged from 10.04 ± 0.03 - 26.23 ± 0.19 mm for all the strains of V. cholerae and for all the extracts. However, the maximum inhibitory zone of diameter (24.27 ± 0.12, 26.23 ± 0.53 mm) were observed in ethanolic extracts of both leaf and rhizome, respectively, against SPAB1 and then followed in SPAB4 and SPAB5 (Fig. 2). Among all the tested extracts, ethanol is highly sensitive and then in methanol, aqueous, and hexane. Moreover, the efficacy of rhizome is better than the leaf with respect to both solvents as well as strains (Table 1). The above study significantly points out that both leaf and rhizome of M. arundinacea possesses a toxicological impact against Cholera.
Presently there is an increasing demand in herbal medicines by the screening of pharmaceutical or bioactive compounds and their ability to treat various diseases [20,25,26]. Marantaceae plants have been received much more attention since they can produce many complex compounds that are useful for the preparation of herbal medicine [27]. To achieve the effect of vibriocidal activity, various extracts, such as aqueous, ethanol, hexane, and methanol of leaf and rhizome were tried and significant activeness results were obtained against ethanol extracts which indicates that the ethanol extracts may possess more bioactive compounds and chemical constituents which are responsible for strong vibriocidal activity [28,29]. Phytoconstituents mainly phenols, flavonoids, tannins, alkaloids, steroids, and terpenoids are responsible for the antimicrobial activity which was confirmed from our previous study on M. arundinacea with ethanolic extracts [20,22].
3.2. MIC Analysis
The MIC values of different solvent extracts of leaves and rhizomes are represented in Table 2, indicating that the variations are dependent not only as per the solvent system but also depend on the strains of V. cholerae. Among the various solvent extracts studied in this assay, ethanolic extract of rhizome exhibited the smallest inhibitory concentration (80.00 ± 10.06 µg/ ml, 90.00 ± 10.82, 100.00 ± 16.11) which indicates the maximum prevention power against SPAB1, SPAB5, and SPAB4, respectively. However, in the case of leaf samples, no such significant variations were observed.
 | Table 1: The inhibition zone diameter (mm) of leaf and rhizome extracts of M. arundinacea against different strains of V. cholerae. [Click here to view] |
To support the vibriocidal activity of M. arundinacea, the MIC values were determined to know the efficacy of concentration against different strains of V. cholerae (SPAB1, SPAB4, and SPAB5). The presence of possible constituents was observed even in a low concentration of solvent extracts of leaf and rhizome. Here, the same ethanol yielding extracts were more powerful than others which indicate also might be due to dissolving or diffusing nature of bioactive compounds present within plant extracts [26]. Moreover, the hydrophobic and hydrogen bonding nature of phenolic compounds from plant extracts attach to membrane proteins, followed by the involvement in the lipid bilayer do inhibition of spreading of tested bacteria as it is a Gram negative in nature, and hence acted as a potent bacteriostatic agent to V. cholerae [30,31]. Ethanolic extracts of the leaf as well as the rhizome have exhibited the minimum inhibition activity against different strains of V. cholerae which confirms that M. arundinacea has capacity to inhibit the growth of diarrhoea causing bacteria.
| Figure 2: Plate showing zone of inhibition against leaf and rhizome ethanolic extracts of M. arundinacea against different strains of Vibrio cholerae. (A) Vibrio cholerae strain SPAB1; (B) Vibrio cholerae strain SPAB4 and (C) Vibrio cholerae strain SPAB5. [Click here to view] |
 | Table 2: The minimum inhibitory concentration (µg/ml) of the ethanolic leaf and rhizome extracts of M. arundinacea against different strains of V. cholerae. [Click here to view] |
4. CONCLUSION
The present study concludes that the ethanol extract of rhizome and leaf of M. arundinacea is a better and safer option to inhibit the spreading of V. cholerae, which is a very challenging pathogen that can cause cholera to humans. For example, is being used for decades as a medicinal plant against various gastrointestinal disturbances, but to our knowledge, this is the first ever report of its efficacy in controlling the growth of V. cholerae. Moreover, the study indicates that the experimental plant contains some natural anti-vibrio compounds which may need further isolation and characterization and that may be used in the future for human health and disease prevention perspective. For that, additional work is essential at the cellular and subcellular level to understand the mechanisms of action of the active plant extracts.
ACKNOWLEDGMENT
The authors are grateful to the Head of the Department, Post Graduate Department of Botany for providing all the experimental facilities.
REFERENCES
1. Kosek M, Bern C, Guerrant RL. The global burden of diarrhoeal disease, as estimated from studies published between 1992 and 2000. Bull World Health Organ 2003;81(3):197–204.
2. Bryce J, Boschi-Pinto C, Shibuya K, Black RE. WHO estimates of the causes of the death in children. Lancet 2005;365:1147–52. CrossRef
3. Harris JB, Larocque RC, Qadri F, Ryan ET, Calderwood SB. Cholera. Lancet 2012;379:2466–76. CrossRef
4. World Health Organization. Cholera 2012. Wkly Epidemiol Rec 2013;88:321–36.
5. Nishibori T, de Vries GC, Rahardjo D, Wasito EB, De I, Kinoshita S, et al. Phenotypic and genotypic characterization of Vibrio cholerae clinically isolated in Surabaya, Indonesia. Jpn J Infect Dis 2011;64(1):7–12.
6. Ried J, Klose KE. Vibrio cholerae and cholera: out of the water into the host. FEMS Microbiol Rev 2002;26:125–39. CrossRef
7. Diallo D, Hveem B, Mahmoud MA, Betge G, Paulsen BS, Maiga A. An international survey of herbal drugs of Gourma district. J Pharm Biol 1999;37(1):80–91. CrossRef
8. Bharati K, Ganguly NK. Cholera toxin: a paradigm of a multifunctional protein. Indian J Med Res 2011;133(2):179–87.
9. Ji L, Larregieu CA, Benet LZ. Classification of natural products as sources of drugs according to the biopharmaceutics drug disposition classification system (BDDCS). Chin J Nat Med 2016;14(12):0888–97. CrossRef
10. Dias DA, Urban S, Roessner U. A historical overview of natural products in drug discovery. Metabolites 2012;2(2):303–36. CrossRef
11. Azzazy MF. Exploratory palynological studies at the Tell el-Daba'a-Avaris archaeological site. PLoS One 2018;13(2):1−30.
12. Ekor M. The growing use of herbal medicines: issues relating to adverse reactions and challenges in monitoring safety. Front Pharmacol 2013;4(177):1–10. CrossRef
13. Panda S, Rout JR, Pati P, Ranjit MR, Sahoo SL. Antimalarial activity of Artemisia nilagirica against Plasmodium falciparum. J Parasit Dis 2018;42(1):22–7. CrossRef
14. Ozkan G, Kamiloglu S, Ozdal T, Boyacioglu D, Capanoglu E. Potential use of turkish medicinal plants in the treatment of various diseases. Molecules 2016;21(257):1–32. CrossRef
15. Aminzare M, Hashemi M, Abbasi Z, Mohseni M, Amiri E. Vibriosis phytotherapy: a review on the most important world medicinal plants effective on Vibrio spp. J Appl Pharm Sci 2018;8(1):170−7.
16. Chander MP, Vijayachari P. Vibriocidal activity of selected medicinal plants used by Nicobarese tribe of Andaman and Nicobar Islands, India. J Pharm Pharmacol 2017;5:164–8. CrossRef
17. Sharma A, Patel VK, Chaturvedi AN. Vibriocidal activity of certain medicinal plants used in Indian folklore medicine by tribals of Mahakoshal region of central India. Indian J Pharmacol 2009;41(3):129–33. CrossRef
18. Azzazi MF, Shahin SI, Nofal AM, Abd El–Rahman AF. Preliminary study on antimicrobial activities of essential oils and Egyptian pollen extract against some phytopathogenic fungi and bacteria. Egypt J Bot 2015;2:363−74.
19. Jayakumar A, Suganthi A. Biochemical and phytochemical analysis of Maranta arundinacea (L.) rhizome. Int J Pharm Pharm Sci 2017;2(3):26–30.
20. Samal P, Rout JR, Das R, Sahoo SL, Padhi BK. Screening and evaluation of phytochemicals from Maranta arundinacea L. Int J Biol Med Res 2018;9(1):6212–7.
21. Ruba AA, Mohan VR. Evaluation of total phenolic and flavonoid contents and in vitro antioxidant activity of rhizome of Maranta arundinacea L. Int J Pharm Sci 2013;4(2):3914–28.
22. Rahman MK, Chowdhury MAU, Islam MT, Chowdhury MA, Uddin ME, Sumi CD. Evaluation of antidiarrhoeal activity of methanolic extract of Maranta arundinacea Linn. Leaves. Adv Pharmacol Sci 2015;2015:1–6. CrossRef
23. Pervez C, Pauli M, Bazerque P. An antibiotic assay by agar well diffusion method. Acta Biol Med Exp 1990;15:113–5.
24. Akinpelu DA, Kolawole DO. Phytochemical and antimicrobial activity of leaf extract of Piliostima thonningii (Schum.). Sci Focus 2004;7:64−70.
25. Lobo R, Prabhu KS, Shirwaikar A, Shirwaikar A. Curcuma zedoaria Rosc. (white turmeric): a review of its chemical, pharmacological and ethnomedicinal properties. J Pharm Pharmacol 2009;61:13–21. CrossRef
26. Choudhury S, Sharan L, Sinha MP. Screening of some commonly used medicinal plants against enteric human pathogen Vibrio cholera. Eur J Med Plants 2015;9(3):1–6. CrossRef
27. Hattori S. Utilization of Marantaceae plants by the Baka hunter-gatherers in southeastern Cameroon. Afr Stud Monogr 2006;33:29–48.
28. Koffi AE, Francis YA, Felix YH, Calixte B, Joseph DA. Comparative study of in vitro susceptibility of clinical and environmental strains of Vibrio cholerae O1 strains to ethanol extracts of Morinda morindoides. Eur J Sci Res 2011;66(2):284–92.
29. Payne A, Mukhopadhyay AK, Deka S, Saikia L, Nandi SP. Anti-vibrio and antioxidant properties of two weeds: Euphorbia serpens and Amaranthus viridis. Res J Med Plants 201;9(4):170–8. CrossRef
30. Kamruzzaman M, Bari SMN, Faruque SM. In vitro and in vivo bactericidal activity of Vitex negundo leaf extract against diverse multidrug resistant enteric bacterial pathogens. Asian Pac J Trop Med 2013;6(5):352–9. CrossRef
31. Akrayi HFS. Antibacterial effect of aqueous extracts of spices and herbs against bacteria isolated from frozen meat. Med J Islamic World Acad Sci 2014;22(1):30−5. CrossRef